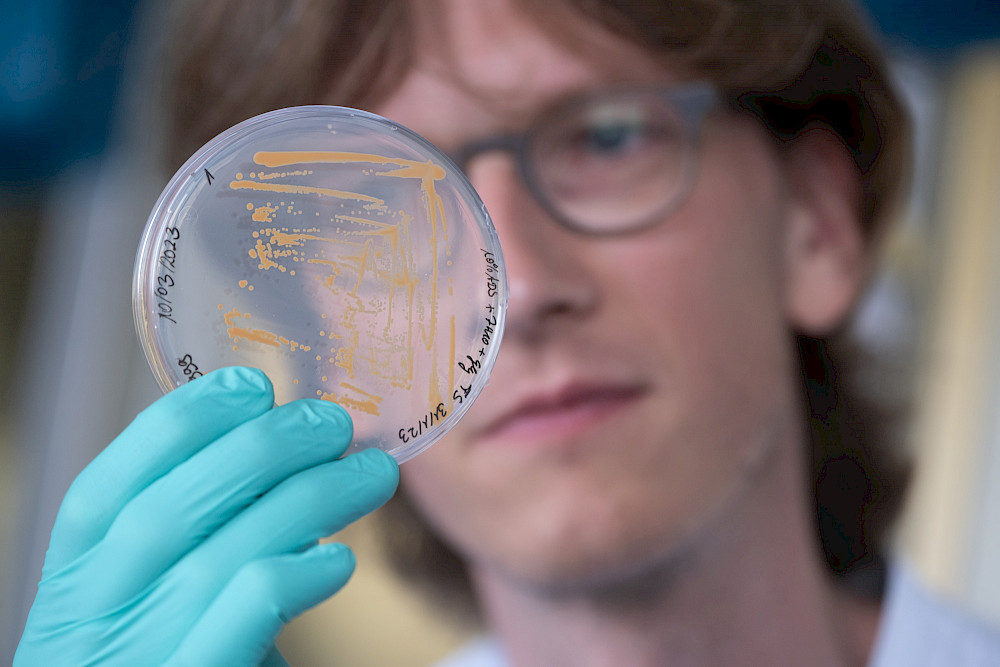
Adrian Richter betrachtet eine Petrischale, in der Bakterien wachsen.

Forschung zu gefährlichen Keimen: Pharmazeut erhält Christian-Wolff-Preis
Der Keim M. abscessus ist für Menschen, die beispielsweise an der Erbkrankheit Mukoviszidose leiden, weltweit eine ernst zu nehmende Gefahr. Wenn er die Lunge befällt, kann er dort tuberkuloseähnliche Infektionen hervorrufen, die zu schweren Gewebsschädigungen und einer schnellen Verschlechterung der Lungenfunktion führen. „Die Infektion ist sehr, sehr schwierig zu behandeln, schwieriger sogar als eine Tuberkulose-Infektion“, sagt Adrian Richter. Das Problem: Der Keim ist resistent gegenüber vielen Antibiotika und es gibt nur ganz wenige Wirkstoffe gegen ihn. Das zu ändern, ist das große Ziel hinter der Forschung von Richter. Seit einigen Jahren befasst sich der Pharmazeut mit der Bekämpfung von Mykobakterien. Für seine Habilitationsschrift „Struktur-Wirkungsbeziehungen antimykobakterieller Substanzen und Entwicklung mikrobiologischer Methoden zu ihrer Charakterisierung” erhält er heute auf der Festveranstaltung der Universität den Christian-Wolff-Preis 2026.
Die Mitte des vergangenen Jahres verteidigte kumulative Habilitation fasst die wichtigsten Ergebnisse seiner bisherigen Studien zusammen. Der Fokus liegt auf neuen Wirkstoffen zur Bekämpfung von M. abscessus und der Entwicklung von Verfahren, die den Keim und dessen Wachstum schneller und effizienter sichtbar machen – Grundlagenarbeit, allerdings noch ohne konkrete Anwendung. „Viele erwarten, dass wir an Medikamenten forschen, die in zwei, drei Jahren von Patienten eingenommen werden“, sagt Richter. Wirkstoffentwicklung aber sei komplex und langwierig – und nur durch ein Zusammenspiel vieler unterschiedlicher Disziplinen und Partner möglich.
Wenn man den Pharmazeuten fragt, an welchem Punkt seine Forschung aktuell ist, spricht er von „vielversprechenden Wirkstoffkandidaten“, die das Wachstum des gefährlichen Keims hemmen. Nächstes Ziel sei, sie so weit zu entwickeln und zu stabilisieren, dass ihre Wirkung in Tieren erprobt werden kann. Bevor es klinische Studien an Menschen geben könnte, vergehen noch Jahre. Ungeduldig darf man da als Wissenschaftler nicht sein. „Aber das wusste ich, bevor ich mich für die Forschung entschieden habe“, sagt Richter. Außerdem seien auch grundlegende Erkenntnisse darüber wertvoll, was genau in den Bakterien passiert, wenn sie mit bestimmten Wirkstoffen in Kontakt kommen. „Wir tragen dazu bei, dass man besser versteht, wie Mykobakterien funktionieren und wo sie empfindlich sind.“
Dass der Forscher heute an diesem Punkt steht, hat auch etwas mit seiner Familie zu tun: Aufgewachsen ist Richter im thüringischen Kyffhäuserkreis als Sohn eines Apothekers. Am Pharmaziestudium haben ihn die vielfältigen naturwissenschaftlichen Ausrichtungen gereizt – Biologie, Chemie, ein bisschen Physik. Im Studium selbst habe ihn dann vor allem die organische Chemie früh interessiert, sagt der Wissenschaftler. Das habe auch an der Vorlesung seines späteren Doktorvaters Prof. Dr. Peter Imming gelegen, in dessen Arbeitsgruppe er schon während des Studiums zu antibakteriellen Wirkstoffen arbeitete. Der mittlerweile pensionierte Professor für Pharmazeutische Chemie sei ein wichtiger Mentor gewesen, für den fachlichen Part ebenso wie für die Planung der Wissenschaftskarriere, sagt Richter. Dazu gehört auch die Vernetzung mit Kooperationspartnern auf Konferenzen: Während seiner Promotion hatte der 37-Jährige dadurch zum Beispiel die Möglichkeit zu Gastaufenthalten am King‘s College London sowie bei einer Pharmafirma in der Nähe von London. „Aus beiden Aufenthalten sind Publikationen entstanden und die Kooperationen wurden fortgesetzt.“
Prägend für seine heutige Forschung war nach Abschluss der Promotion 2017 dann ein zweijähriger Forschungsaufenthalt an der University of British Columbia in Vancouver, Kanada. Grundsätzlich lag der Schwerpunkt dort zwar auch auf einem Wirkstoff gegen Mykobakterien. Während es in Halle aber immer darum ging, Substanzen im Chemielabor zu synthetisieren, konzentrierte sich Richter nun auf den mikrobiologischen Aspekt. Konkret forschte er mit Tuberkulose-Bakterien, in einem Hochsicherheitslabor mit strengen Sicherheitsvorkehrungen. Die ersten Monate habe er damals damit verbracht, neue Arbeitsmethoden und das Handling der gefährlichen Mikroorganismen zu lernen, erinnert sich der Wissenschaftler. „Es war schon ungewöhnlich, dass jemand mit Expertise in medizinischer Chemie auch mikrobiologisch arbeitet.“
Zurück in Halle bot sich Richter die Chance für sein Habilitationsprojekt zum Mykobakterium M. abscessus, das auch von der Deutschen Forschungsgemeinschaft gefördert wurde. Für seine Arbeit nutzt er auch ein spezielles Labor im Fraunhofer-Institut für Zelltherapie und Immunologie IZI am Weinberg Campus in Halle, in dem er direkt an M. abscessus arbeiten kann. Ein Glücksfall, wie der Forscher sagt: Das spare Zeit, weil er nicht auf externe Auftragnehmer angewiesen ist. Zudem könne er viel mehr Aspekte bei der Wirkstofftestung an den Bakterien berücksichtigen.
In seiner Zeit als Habilitand hat Richter selbst bereits 900.000 Euro an Drittmitteln eingeworben. Zudem hat er in seiner Arbeitsgruppe Promovierende betreut. Drei Promotionen sind abgeschlossen, zwei laufen noch. Seit Oktober 2025 vertritt Richter für ein Jahr die Professur von Peter Imming – womit auch ein stärkerer Fokus auf die Lehre verbunden ist. Im Anschluss kann er dank der externen Förderung weiter an seinem Projekt arbeiten.
Und wenn er weder forscht noch lehrt? Dann fotografiert Richter gern, bevorzugt urbane Motive wie U-Bahnhöfe oder Sportplätze. Und er imkert in seiner alten Heimat im Kyffhäuserkreis. „Ich fand schon in der Abi-Zeit einfach interessant, wie so ein Bienenvolk funktioniert.“ Das Hobby passt auch gut in den Zeitrahmen des engagierten Forschers. „Den überwiegenden Teil der Arbeit machen schließlich die Bienen selbst.“
Festveranstaltung und Übergabe der Universitätspreise
Die MLU veranstaltet heute für ihre Promovenden und Habilitanden eine Festveranstaltung in der Nationalen Akademie der Wissenschaften Leopoldina. Nachwuchswissenschaftlerinnen und Nachwuchswissenschaftler, die ihre Promotion mit der Bestnote „summa cum laude“ abgeschlossen haben, werden zudem mit der Luther-Urkunde der MLU ausgezeichnet. Weiterhin werden die Universitätspreise für besonders herausragende Arbeiten vergeben.
Neben dem mit 1.500 Euro dotierten Christian-Wolff-Preis für PD Dr. Adrian Richter werden die Dorothea-Erxleben-Preise 2026 vergeben - jeweils zwei Mal in den Kategorien Sozial- und Geisteswissenschaften sowie Lebens- und Naturwissenschaften vergeben und jeweils mit einer Dotierung von 500 Euro. Dr. Doris Günther-Kriegel erhält den Preis für ihre Dissertation „Fairer Handel und globale Ordnung. Eine religionswissenschaftliche Kategorienkritik“. Dr. Oscar Laurenz Prust erhält ihn für seine Dissertation „Parlamentarische Rüstungskontrolle: Neue Technologien und Sicherheitspolitik in der Kontroverse“. Zudem erhält Dr. Pablo Castro Sanchez-Bermejo den Preis für seine Dissertation zum Thema „Patterns of intraspecific and intraindividual trait variation in trees along experimental diversity gradients“ und Dr. Arthur Groß für seine Arbeit „Potential and constraints of organic soil amendments for long-term carbon storage and soil improvement".
Mit dem Anton-Wilhelm-Amo-Preis 2026, der mit 1.000 Euro dotiert ist, wird Eileen Richter für ihre Masterarbeit „Warum scheitern Lernende an Prozentaufgaben? Eine Untersuchung der Herausforderungen im Zusammenhang mit Aufgaben- und Antwortformaten“ ausgezeichnet. Den mit 1.000 Euro dotierten DAAD-Preis 2026 erhält Albert Arzumanian für seine besonderen akademischen Leistungen und sein bemerkenswertes gesellschaftliches und interkulturelles Engagement.